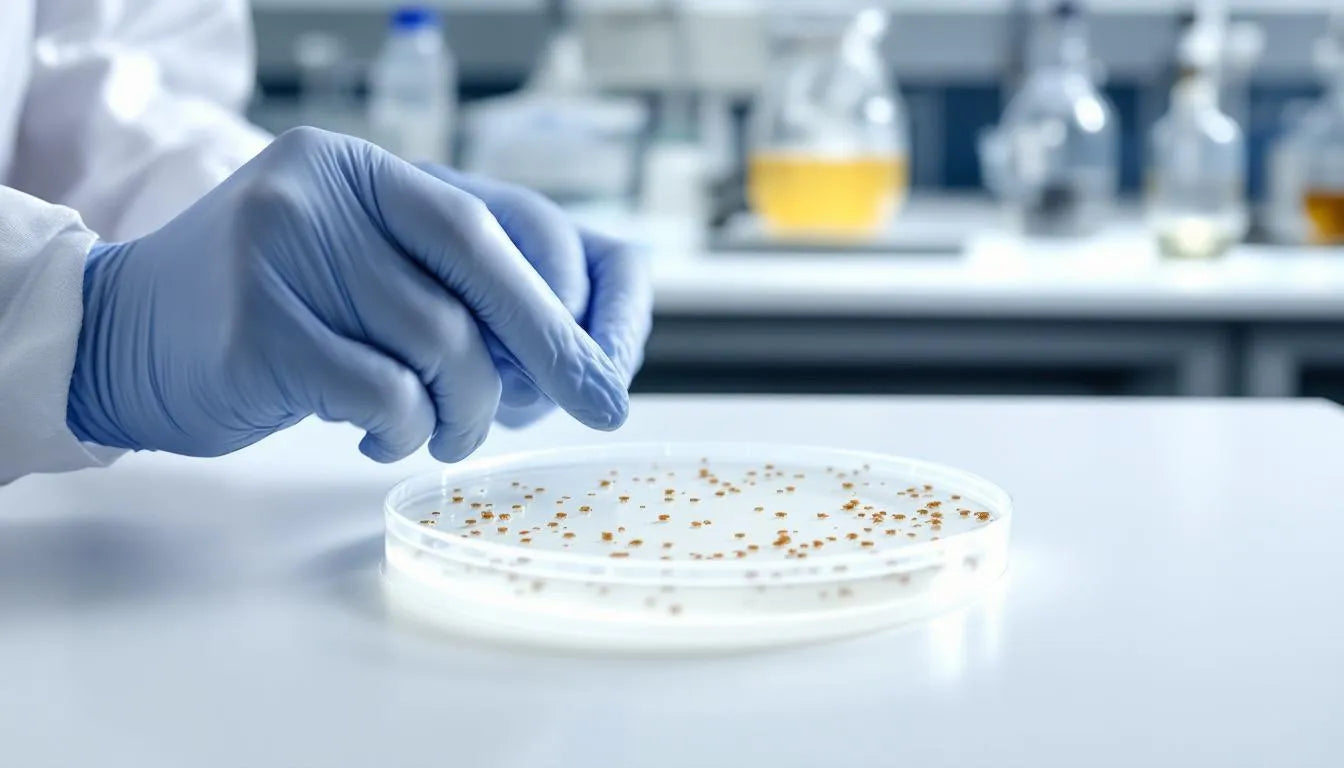
Person cultivating fungal cultures on agar plate in lab

⬇️ Prefer to listen instead? ⬇️

- 🧬 DNA sequencing reclassified most fungi that lacked a known sexual stage as ascomycetes or basidiomycetes.
- ⚕️ Asexual fungi include important species like Penicillium, which led to the discovery of antibiotics.
- 🌾 Trichoderma species are used a lot in farming to control pests and keep soil healthy.
- 🧫 Many asexual fungi can adjust well through gene changes and gene sharing, even without sexual reproduction.
- 🔍 "Deuteromycota" is still a helpful term in teaching and research, even if it is no longer used for official classification.

The Puzzle of the “Imperfect” Fungi
Fungi Imperfecti—also known as Deuteromycota or the “imperfect fungi”—are a group of fungi once classified together because they did not have a clear sexual stage in their life cycle. This missing part confused early mycologists, so they placed these species into their own category, even though they had major impacts on medicine, industry, farming, and science. Today, new genetic tools have reclassified many of these fungi into their proper groups, but the concept of Fungi Imperfecti still matters for understanding how different fungi grow and reproduce. Whether you're studying wild species or cultivating related fungi in Mushroom Grow Bags or a Monotub, this category helps explain why some fungal groups took longer to understand than others.

Why Were They Called “Imperfect”?
The word "imperfect" might sound negative, but in science, it just meant there was a gap in what we knew. It was not a judgment of how well they worked or their value. Old ways of classifying fungi relied on looking at their shapes during sexual reproduction. Scientists mostly knew fungi by structures like asci or basidia, which formed during sexual reproduction. These structures let people group fungi into types such as Ascomycota and Basidiomycota.
But, many fungi only showed up in their asexual forms. They reproduced through special spores called conidia. These asexual forms did not have the sexual structures needed to fit well into the usual fungal groups. So, scientists made a general group called Deuteromycota (from the Greek for "second fungi"). This was a place for these species that they did not fully understand.
The fungi were “imperfect” only because their full way of reproducing could not be seen. This made it hard to place them in the usual way.

How Sexual Reproduction Helps Classify Fungi
To understand how fungi are named and grouped, we need to know why sexual reproductive stages are important for classification. Fungi can have different forms: the teleomorph is the sexual form, and the anamorph is the asexual form. For a long time, the teleomorph helped classify fungi. A fungus was grouped based on the sexual structures seen when it made spores.
Asexual fungi made this model harder to use. Without signs of sexual reproduction, it was impossible to classify them based on teleomorphs. To deal with this, the Deuteromycota group was made. It collected asexual fungi known only by their anamorphs. For hundreds of years, this was the only way to sort the many fungi found when their full life cycle was unknown.
The problem was, this method gave little idea about how they were related over time. Just seeing the asexual form gives limited information about their genes and family lines. This is where molecular biology changed everything.

DNA Sequencing Changed Everything
The 1990s and early 2000s brought new, powerful tools to fungal biology. DNA barcoding was one. It made it possible to figure out how species were related by looking at their genes, not just by what they looked like.
Internal Transcribed Spacer (ITS) sequencing was an important tool in this big change. It works like a genetic “barcode” for finding fungi. Researchers began sequencing samples of the fungi imperfecti. Then, they compared their DNA to known genetic data of sexual fungi. These studies showed that many “imperfect” fungi were closely related to well-defined sexual groups. This was especially true for Ascomycota, the largest group of fungi.
This genetic information was so helpful that it made the phylum Deuteromycota no longer useful for classifying fungi. Fungi once put into this group were moved to other groups based on similar genes:
- Most were reclassified under Ascomycota.
- A smaller number were put into Basidiomycota.
- A few turned out to be new types entirely. This showed what was wrong with classifying fungi only by their shape.
Today, names like Deuteromycota are mostly just names or old references. DNA sequencing gave us the missing part of the reproduction story. And then, it gave new ways to sort the fungal kingdom more accurately.

Famous Members: Fungi Imperfecti That Changed the World
The group of asexual fungi includes some of the most important organisms ever found. This is especially true in medicine, biotechnology, and industry. Here are some examples of fungi once called Fungi Imperfecti:
Penicillium notatum
- P. notatum is perhaps the most famous member of the former Deuteromycota. It was the fungus behind the discovery of penicillin. In 1928, Alexander Fleming saw that this mold stopped Staphylococcus bacteria from growing. This started the age of antibiotics.
Aspergillus
-
Aspergillus is a useful type of fungus. Its species are used in:
- Making soy products
- Sake and miso production
- Making a lot of citric acid
- Some species are also used to make enzymes for detergents, fabrics, and biofuels.
Candida albicans
- This is a yeast often found in the human body. While usually harmless, Candida albicans can become germs that cause problems, especially in people with weak immune systems. It is a main cause of yeast infections and has helped a lot with medical fungus research.
Trichoderma
-
Trichoderma species are used widely in farming and cleaning up the environment. They can:
- Fight germs in the soil as natural pest control.
- Make plants stronger against disease.
- Break down dead plants and animals into food for crops.
These examples show one important thing: not having sexual reproduction does not mean they are not useful. Asexual fungi continue to have a big effect on our natural world, health, and money.
Cultivating Asexual Fungi: Can You Grow Them?
Yes—and often with good results. Many fungi once known as Deuteromycota can be grown and are also worth money. These fungi do not rely on sexual reproduction. So, they often grow fast and in a steady way. This makes them good choices for growing in a controlled setting.
Common ways to grow them include:
- Solid-state fermentation: This is often used for Aspergillus to make enzymes and organic acids.
- Liquid culture and inoculum preparation: Used for Trichoderma types to make soil better.
- Surface cultivation and culturing on agar plates: Used for Penicillium types in labs or food making.
Companies like Zombie Mushrooms offer grow kits or treated growing material that include types of useful asexual fungi. These setups are good for new growers and hobbyists. They offer a way into growing fungi without needing a lot of lab practice.

How Asexual Fungi Thrive Without Sexual Reproduction
At first, asexual life cycles seem like a drawback. After all, sexual reproduction mixes up DNA to make new types. This helps organisms change over time. But asexual fungi have found ways to adjust and survive:
1. They Change Their Genes Quickly
These fungi reproduce fast, even in bad conditions. This quick copying lets mutations (gene changes) build up. Some of these mutations give them good traits, helping them change fast.
2. They Can Get Genes From Other Organisms (HGT)
New studies show that fungi can get genes from bacteria, plants, and other fungi. Especially in soil, Trichoderma and Aspergillus species have shown they can pick up genes from other organisms. This helps them break down plants or deal with tough conditions.
3. They Can Spread Fast
Successful types can spread quickly through conidia—asexual spores. These spores spread easily and grow when conditions are good. This lets many copies of them take over new places fast.
But, these good points also come with some risks:
- Less gene variety: This can make it harder for them to change over long periods.
- Harmful gene changes build up: Without mixing genes, bad changes can collect.
- They can't handle changes well: Many copies of the same fungus might have trouble if things change fast.
Even with these problems, asexual fungi show they are tough and good at living in certain places.

Why These Fungi Still Matter
The name Deuteromycota is no longer used as an official group for classifying fungi. But, it is still important for teaching and history. Many science databases and teaching materials still talk about fungi this way, especially when discussing their asexual forms.
And, some fungi studied today are only known by their asexual forms. Until a sexual stage is found (in nature or a lab), researchers use information about their asexual features and genes.
Understanding these fungi helps explain some bigger ideas in biology:
- How species change and get used to things faster
- Genes moving between different types of living things
- The many different life cycles of living things

Where Are They Now Classified?
When we started classifying fungi using genes, most of the fungi once called Deuteromycota were put into new groups:
- Ascomycota now holds between 75–90% of these fungi.
- Basidiomycota includes a smaller part, mainly based on similar genes.
- Some are still waiting to be classified more with gene and growth data.
These fungi are listed in databases like:
Modern biology has mostly fixed the wrong classification of these fungi. Still, school and real-world situations get help from the clear way the “imperfect fungi” label describes them.

Modern-Day Effects and Uses
Fungi once called Deuteromycota are still very important. Whether or not a sexual phase is known, they affect many areas:
Medicine
- Making antibiotics (Penicillium, Cephalosporium)
- Research on good bacteria involving Candida and other yeast
- Things that fight fungus and change the immune system from asexual fungi found in the ocean
Biotechnology
- Making enzymes: For laundry detergents, paper work, cheese aging
- Biofuels: Enzyme mixes from Trichoderma to break down plant material
- Making bioplastics and other molecules using fungi
Agriculture and Ecology
- Cleaning soil with fungi like Trichoderma
- Natural pest control instead of chemical ones
- Using fungi to filter and make compost for waste
The main point? Not having a known sexual phase does not make them less useful. These fungi continue to change the world.

Common Wrong Ideas About Fungi Imperfecti
Let’s clear up some common wrong ideas:
- ❌ "Imperfect" means weak or not fully grown — False. Some are among the most successful fungal types in today's natural world and industry.
- ❌ Asexual fungi don't change — Incorrect. They adjust fast by gene changes and genes moving around.
- ❌ They don't matter anymore — Not at all. In fact, they are very important in medicine, soil science, and biotechnology.

For Growers and Curious Mycologists
For those who want to try working with asexual fungi, there are many things you can do:
Cultivation Opportunities:
- Grow Trichoderma to make your compost pile or garden soil better.
- Add Aspergillus oryzae to fermented foods to make savory soy sauce.
- Grow Penicillium for its famous marbled cheese or to try making useful compounds at home.
Zombie Mushrooms and similar stores offer spore syringes, plug spawn, and culture slants that include species once put into the Deuteromycota group. These are easy to use for learning experiments or growing at home.
Are Fungi Imperfecti Still Important? (Yes)
The term Fungi Imperfecti is no longer an official group of fungi. But, it is still very important for teaching, science, and everyday uses. These asexual fungi continue to earn their place in human history and science moving forward, whether they are making crops better, saving lives, or teaching basic biology.
Accept what makes them special, question how they are named, and see what they can do. Because in the world of fungi, the “imperfect” ones are often very special.
References
Hawksworth, D. L., & Ainsworth, G. C. (1983). Ainsworth & Bisby's Dictionary of the Fungi (7th ed.). CAB International.
Blackwell, M. (2011). The Fungi: 1, 2, 3… 5.1 million species? American Journal of Botany, 98(3), 426–438. https://doi.org/10.3732/ajb.1000298
Taylor, J. W., Jacobson, D. J., & Fisher, M. C. (2000). Phylogenetic Species Recognition and Species Concepts in Fungi. Fungal Genetics and Biology, 31(1), 21–32. https://doi.org/10.1006/fgbi.2000.1228
Pitt, J. I., & Hocking, A. D. (2009). Fungi and Food Spoilage (3rd ed.). Springer. https://doi.org/10.1007/978-0-387-92207-2
Nosanchuk, J. D., & Casadevall, A. (2006). The contribution of melanin to microbial pathogenesis. Cellular Microbiology, 8(12), 203–213. https://doi.org/10.1111/j.1462-5822.2006.00751.x



